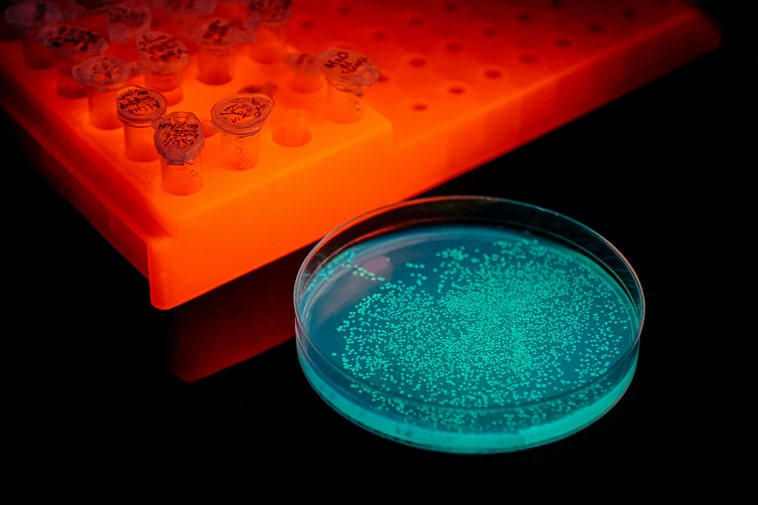

Новая фармацевтика и светящиеся клетки
Одно из приоритетных направлений работы красноярских ученых — создание клеточных линий с трансмембранными рецепторами (белками), которые могут служить моделями для тестирования новых лекарств.
Трансмембранные рецепторы помогают передавать сигналы внутри клетки, управляя ее ростом и другими важными процессами. Сбои в работе таких рецепторов могут приводить к серьёзным заболеваниям: раку, диабету, нейродегенеративным патологиям (например, болезни Альцгеймера и Паркинсона).

Именно поэтому научное сообщество сосредоточилось на создании лекарств, которые могут «чинить» эти белки. Красноярские исследователи, в свою очередь, разрабатывают клеточные модели, которые помогут быстрее и точнее тестировать такие препараты.
«Сегодня около 30 % всех одобренных лекарств действуют через трансмембранные рецепторы, а рынок препаратов на их основе к 2030 году достигнет 5 миллиардов долларов. Однако многие такие рецепторы до сих пор недостаточно изучены, что делает их перспективными мишенями для новых разработок. Спрос на такие клеточные линии огромен», — рассказывает Евгений Высоцкий, кандидат биологических наук, заведующий лабораторией фотобиологии Института биофизики СО РАН.

В Красноярске создают линии, которые не просто несут нужные рецепторы, но и снабжены встроенными светящимися белками, реагирующими на изменения активности рецептора или концентрации важных для жизнедеятельности клетки веществ. Такой подход позволяет в реальном времени отслеживать реакцию клетки на потенциальный будущий препарат.

Репортёры регистрируют сигналы и излучают свет, который фиксируется приборами, что делает процесс высокоточным и наглядным.
Диагноз при помощи света
Параллельно красноярские ученые разрабатывают новые подходы к диагностике заболеваний. Один из ярких примеров — метод раннего обнаружения рассеянного склероза, разработанный совместно с Институтом химической биологии и фундаментальной медицины СО РАН (Новосибирск). Раньше диагноз ставили только по клиническим симптомам, что часто приводило к ошибкам. Новый, более точный подход основан на анализе биомаркеров в крови. Специалисты отмечают, что все исследования этого метода прошли успешно и технология готова к применению.

Другой проект — тест на рак мочевого пузыря, основанный на анализе мочи. Он избавляет пациентов от болезненных процедур при диагностике. Также разработан способ определения гликированного гемоглобина — важного показателя у пациентов с сахарным диабетом. Он дает более полную картину состояния пациента, чем традиционный анализ на глюкозу.
Основой всех этих решений стали репортерные белки, способные излучать свет в ответ на специфические биохимические сигналы. Благодаря многолетним исследованиям, красноярским ученым удалось повысить их чувствительность и стабильность.

При помощи химических модификаций и генной инженерии белки адаптируют под конкретные задачи, например, для обнаружения гормонов, онкомаркеров или генетических мутаций. С их помощью можно «подсветить» ключевые процессы в организме — будь то воспаление, активность рецептора или уровень определенного гормона. Такие методы обеспечивают исключительно высокую чувствительность, но при этом остаются безопасными и технологически доступными.

«Когда мы говорим о молекулярной диагностике, важно понимать, что для этого необходимы определенные молекулы, связанные с конкретными диагнозами — биомаркеры. Наша задача — научиться их распознавать. Мы разработали технологии, позволяющие превращать светящиеся белки в специфические метки — с помощью химических модификаций и методов генной инженерии. В результате получаем универсальный инструмент для высокоточной диагностики. По сути, мы можем „настроить“ белок на любую молекулярную мишень — гормон, онкомаркер, кардиомаркер или генетический вариант, связанный с риском заболевания. Это проверено в серии испытаний: наши методы показали чувствительность, сравнимую с изотопным анализом, но при этом они безопаснее, проще в применении и подходят для масштабного использования. Такой подход открывает путь к персонализированной медицине и широкому спектру экспресс-диагностики — быстрой, точной и доступной», — отмечает доктор биологических наук главный научный сотрудник Института биофизики СО РАН Людмила Франк.
Путь от идеи к производству
Несмотря на успехи, дальнейшее исследование и внедрение таких технологий требует инфраструктуры. Необходимо обучать новое поколение специалистов, а также сформировать исследовательский центр для доклинического тестирования лекарств. К тому же системы требуют специализированного оборудования, которого в России нет.
Пока у ученых в планах развитие сотрудничества с ведущими лабораториями Китая, расширение штата и создание собственной приборной базы. Уже собран прототип планшетного биолюминометра — первого в России прибора, фиксирующего излучение от светящихся белков, и соответствующего программного обеспечения.
«В настоящее время также готовится заявка на мегагрант правительства России, который поддержит разработку технологической платформы для ускорения и удешевления доклинического скрининга терапевтических препаратов. Одним из ключевых направлений станет поиск соединений для лечения нейродегенеративных заболеваний. Развитие этого направления позволит не только внести вклад в фундаментальную науку, но и создаст востребованные технологии для фармацевтической отрасли, сократив зависимость от зарубежных поставщиков и открыв новые возможности для разработки оригинальных лекарственных препаратов», — говорит о перспективах Евгений Высоцкий.
Специалисты отмечают, что необходимо переходить от лабораторных разработок к реальному производству, сокращать зависимость от иностранных технологий и создавать предпосылки для появления оригинальных российских лекарств. Светящиеся белки — не просто эффектный биологический феномен, а универсальный инструмент, способный трансформировать подход к диагностике и лечению самых сложных заболеваний.
Материал подготовлен при поддержке Минобрнауки России в рамках Десятилетия науки и технологий, фото предоставлено КНЦ СО РАН.